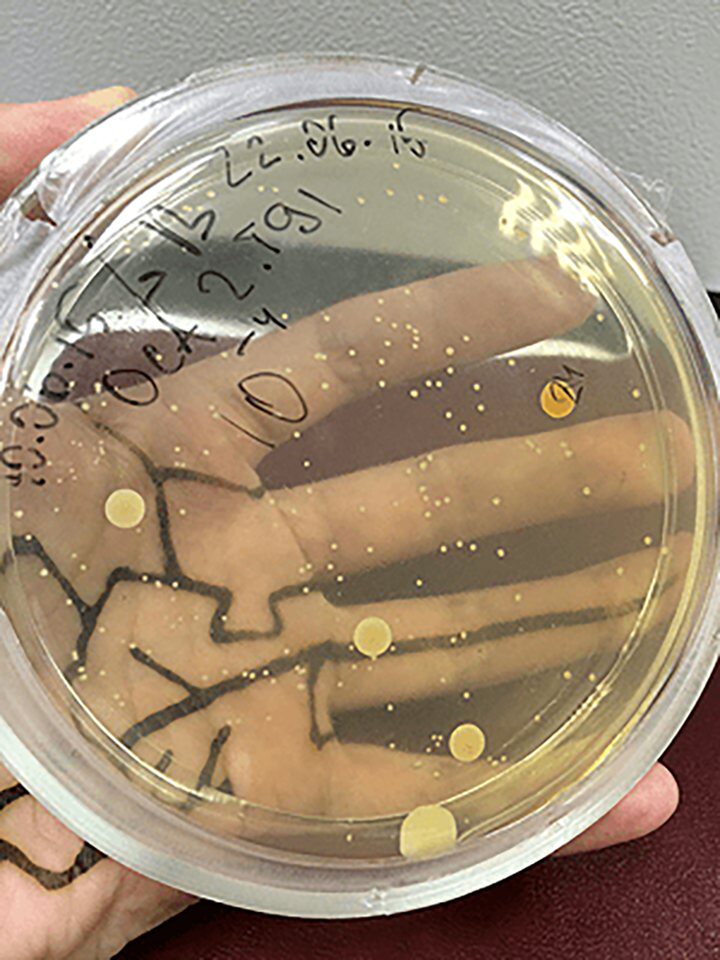

-
Лауреат Пулитцеровской премии писатель Кормак Маккарти (Cormac McCarthy) рассказывает, как написать статью, за которую не будет стыдно, и дает рекомендации по созданию понятного и интересного текста. Этой переводной и слегка адаптированной заметкой мы продолжим давно существующий на «Биомолекуле» цикл «ОколоНауки», а в частности — материал «11 простых правил написания научных обзоров».
-
3628Вот Сколковский институт науки и технологий. А это Центр наук о жизни в Сколковском институте науки и технологий. А вот лаборатория изучения метаболизма прокариот Центра наук о жизни в Сколковском институте науки и технологий. А здесь ключевые слова лаборатории изучения метаболизма прокариот Центра наук о жизни в Сколковском институте науки и технологий: Genome mining, метод Topo-Seq, CRISPR, ДНК-гираза, метод HI-C, микроцины, гонка вооружений фагов и бактерий — и это лишь малая часть. В статье читатель узнает подробности внутренней жизни лаборатории и ее исследовательской работы.
-
Сколковский институт науки и технологий (Сколтех) — одно из нескольких образовательных учреждений на территории инновационного центра Сколково, часто упоминаемого в прессе, когда речь заходит про новые технологии и предпринимательство. Эта статья продолжает спецпроект, посвященный биологическому направлению Сколтеха. В ней рассказывается о том, как работает и развивается магистерская программа Сколтеха по направлению «Биотехнология» и как ее студенты занимаются наукой и инновациями.
-
Название «Сколтех» часто всплывает в российской и зарубежной прессе: то в связи с открытием нового кампуса, то в связи с финансированием или получением международной аккредитации программ для учащихся. Этой статьей мы открываем новый спецпроект, посвященный функционированию самой близкой читателю «Биомолекулы» части Сколтеха — биологической. В нем читатель узнает из первых рук, как работает, развивается и преодолевает трудности Центр наук о жизни Сколтеха!
-
Биология — одна из самых быстро развивающихся наук современности. Ее успехи за последние десятилетия полностью изменили мир и даже позволили нам приблизиться к мечте о победе над смертельными заболеваниями. Однако за столь быстрыми изменениями в технологиях не всегда успевает система образования и подготовки новых специалистов. О том, чему нужно учиться современным биологам, чтобы найти и сохранить свое место в биотехе через пять–десять лет, мы поговорили с Хайнцем Шмидтом, директором российского отделения фармацевтической компании Merck.
-
При экспертизе грантовых заявок в российские фонды поддержки фундаментальной науки я обратил внимание на повторяющиеся ошибки подготовки таких проектов, которые часто приводят к их проигрышу в конкурсе. Подготовленные мной по собственному опыту небольшие пояснения, конечно, не сгенерируют новые научные идеи, зато помогут облечь их в ту форму, которую лучше воспримут эксперты фондов.
-
«Бластим» — это не просто кадровое агентство. Это агентство в биотехе, да еще и в России! Мы помогаем биотехнологическим компаниям найти сотрудников, а соискателям — найти работу на доске вакансий. Организуем интенсивы по биоинформатике. Знаем сами и расскажем вам: где работать в биотехе, где этому учиться, у кого просить деньги для стартапа, как найти сотрудника и в кого инвестировать. Верим: биотеху в России быть!
-
2062Статья на конкурс «био/мол/текст»: Создание микробиологических препаратов для деструкции различных загрязнителей в почве — востребованное и перспективное направление. В данном руководстве рассматриваются основные этапы процесса изготовления биопрепарата и получения разрешения на его промышленное производство и использование в России. В тексте присутствуют конкретные практические указания, теоретическая часть, ссылки на статьи и ГОСТы, а также примеры — результаты, собственноручно полученные на тех или иных этапах создания биопрепарата — биодеструктора инсектицида ДДТ.
-
Биология не раз переживала новое рождение: быв сначала «полевой» наукой, изучавшей животных и растения, в XX веке она значительно переместилась в лаборатории, концентрируясь на молекулярных основах жизни и наследственности. В XXI веке история двинулась дальше: многие эксперименты теперь проводятся на компьютере, а материалом для изучения являются последовательности белков и ДНК, а также информация о строении биологических молекул. В этой статье мы дадим несколько советов тем, кто решил связать свою карьеру с компьютерной биологией, став, тем самым, биоинформатиком.
-
Как известно, чтобы мало зарабатывать, надо много и упорно учиться. Так является ли работа ученого — а к ней упомянутая максима применима в полной мере (по крайней мере, в России) — достойной таких скорбных усилий? Наш ответ — «да». И вот почему: ученые обладают изрядной свободой в выборе объектов своих исследований и нетривиальными возможностями карьерного роста, а в научных лабораториях, университетах и международных сообществах царит практически пушкинский дух товарищества, вдохновляющий на то, чтобы сделать свой вклад в текущий исторический момент эпохи биологических революций. В этом эссе будут изложены девять причин, по которым карьера ученого может заинтересовать молодых людей, не ищущих легких путей в жизни.


- Лента
- Спецпроекты
- ▶Подкаст
-
Конкурс
- О конкурсе «Био/мол/текст»
- «Био/мол/текст»-2025/2026
- «Био/мол/текст»-2024/2025
- «Био/мол/текст»-2023/2024
- «Био/мол/текст»-2022/2023
- «Био/мол/текст»-2021/2022
- «Био/мол/текст»-2020/2021
- «Био/мол/текст»-2019
- «Био/мол/текст»-2018
- «Био/мол/текст»-2017
- «Био/мол/текст»-2016
- «Био/мол/текст»-2015
- «Био/мол/текст»-2014
- «Био/мол/текст»-2013
- «Био/мол/текст»-2012
- «Био/мол/текст»-2011
- Объявления
- Авторы
- Партнеры
- Поддержать
Публикации
—
Темы
—
Авторы
—
Комментарии
—
Поиск не дал результатов
По вашему запросу ничего не найдено
- Медицина
- SARS-CoV-2
- «Биомолекула» — Forbes
- Аллергия
- Антибиотики
- Атеросклероз
- Аутоиммунитет
- Боль
- ВИЧ/СПИД
- Вакцины
- Вирус Зика
- Вирус Эбола
- Генная терапия
- Грипп
- Депрессия
- Дерматология
- Диагностика
- Здравоохранение
- Нейродегенерация
- Никотин
- Онкология
- Персонализированная медицина
- Питание
- Сон
- Стволовые клетки
- Фармакология
- Эпилепсия
- Биология
- «Сухая» биология
- Антропология
- Бионика
- Биофизика
- Вирусология
- Вопросы пола
- ГМО
- Генетика
- Иммунология
- Микробиология
- Нейробиология
- Носимые технологии
- Психогенетика
- Синтетическая биология
- Старение
- Структурная биология
- Цитология
- Эволюционная биология
- Экология
- Эмбриология
- Эпигенетика
- Этология
- Биомолекулы
- GPCR
- АФК
- Амилоиды
- Биомембраны
- Гормоны растений
- ДНК
- Ионные каналы
- МГЭ
- Матрикс
- Нейромедиаторы
- РНК
- Рецепторы
- Хроматин